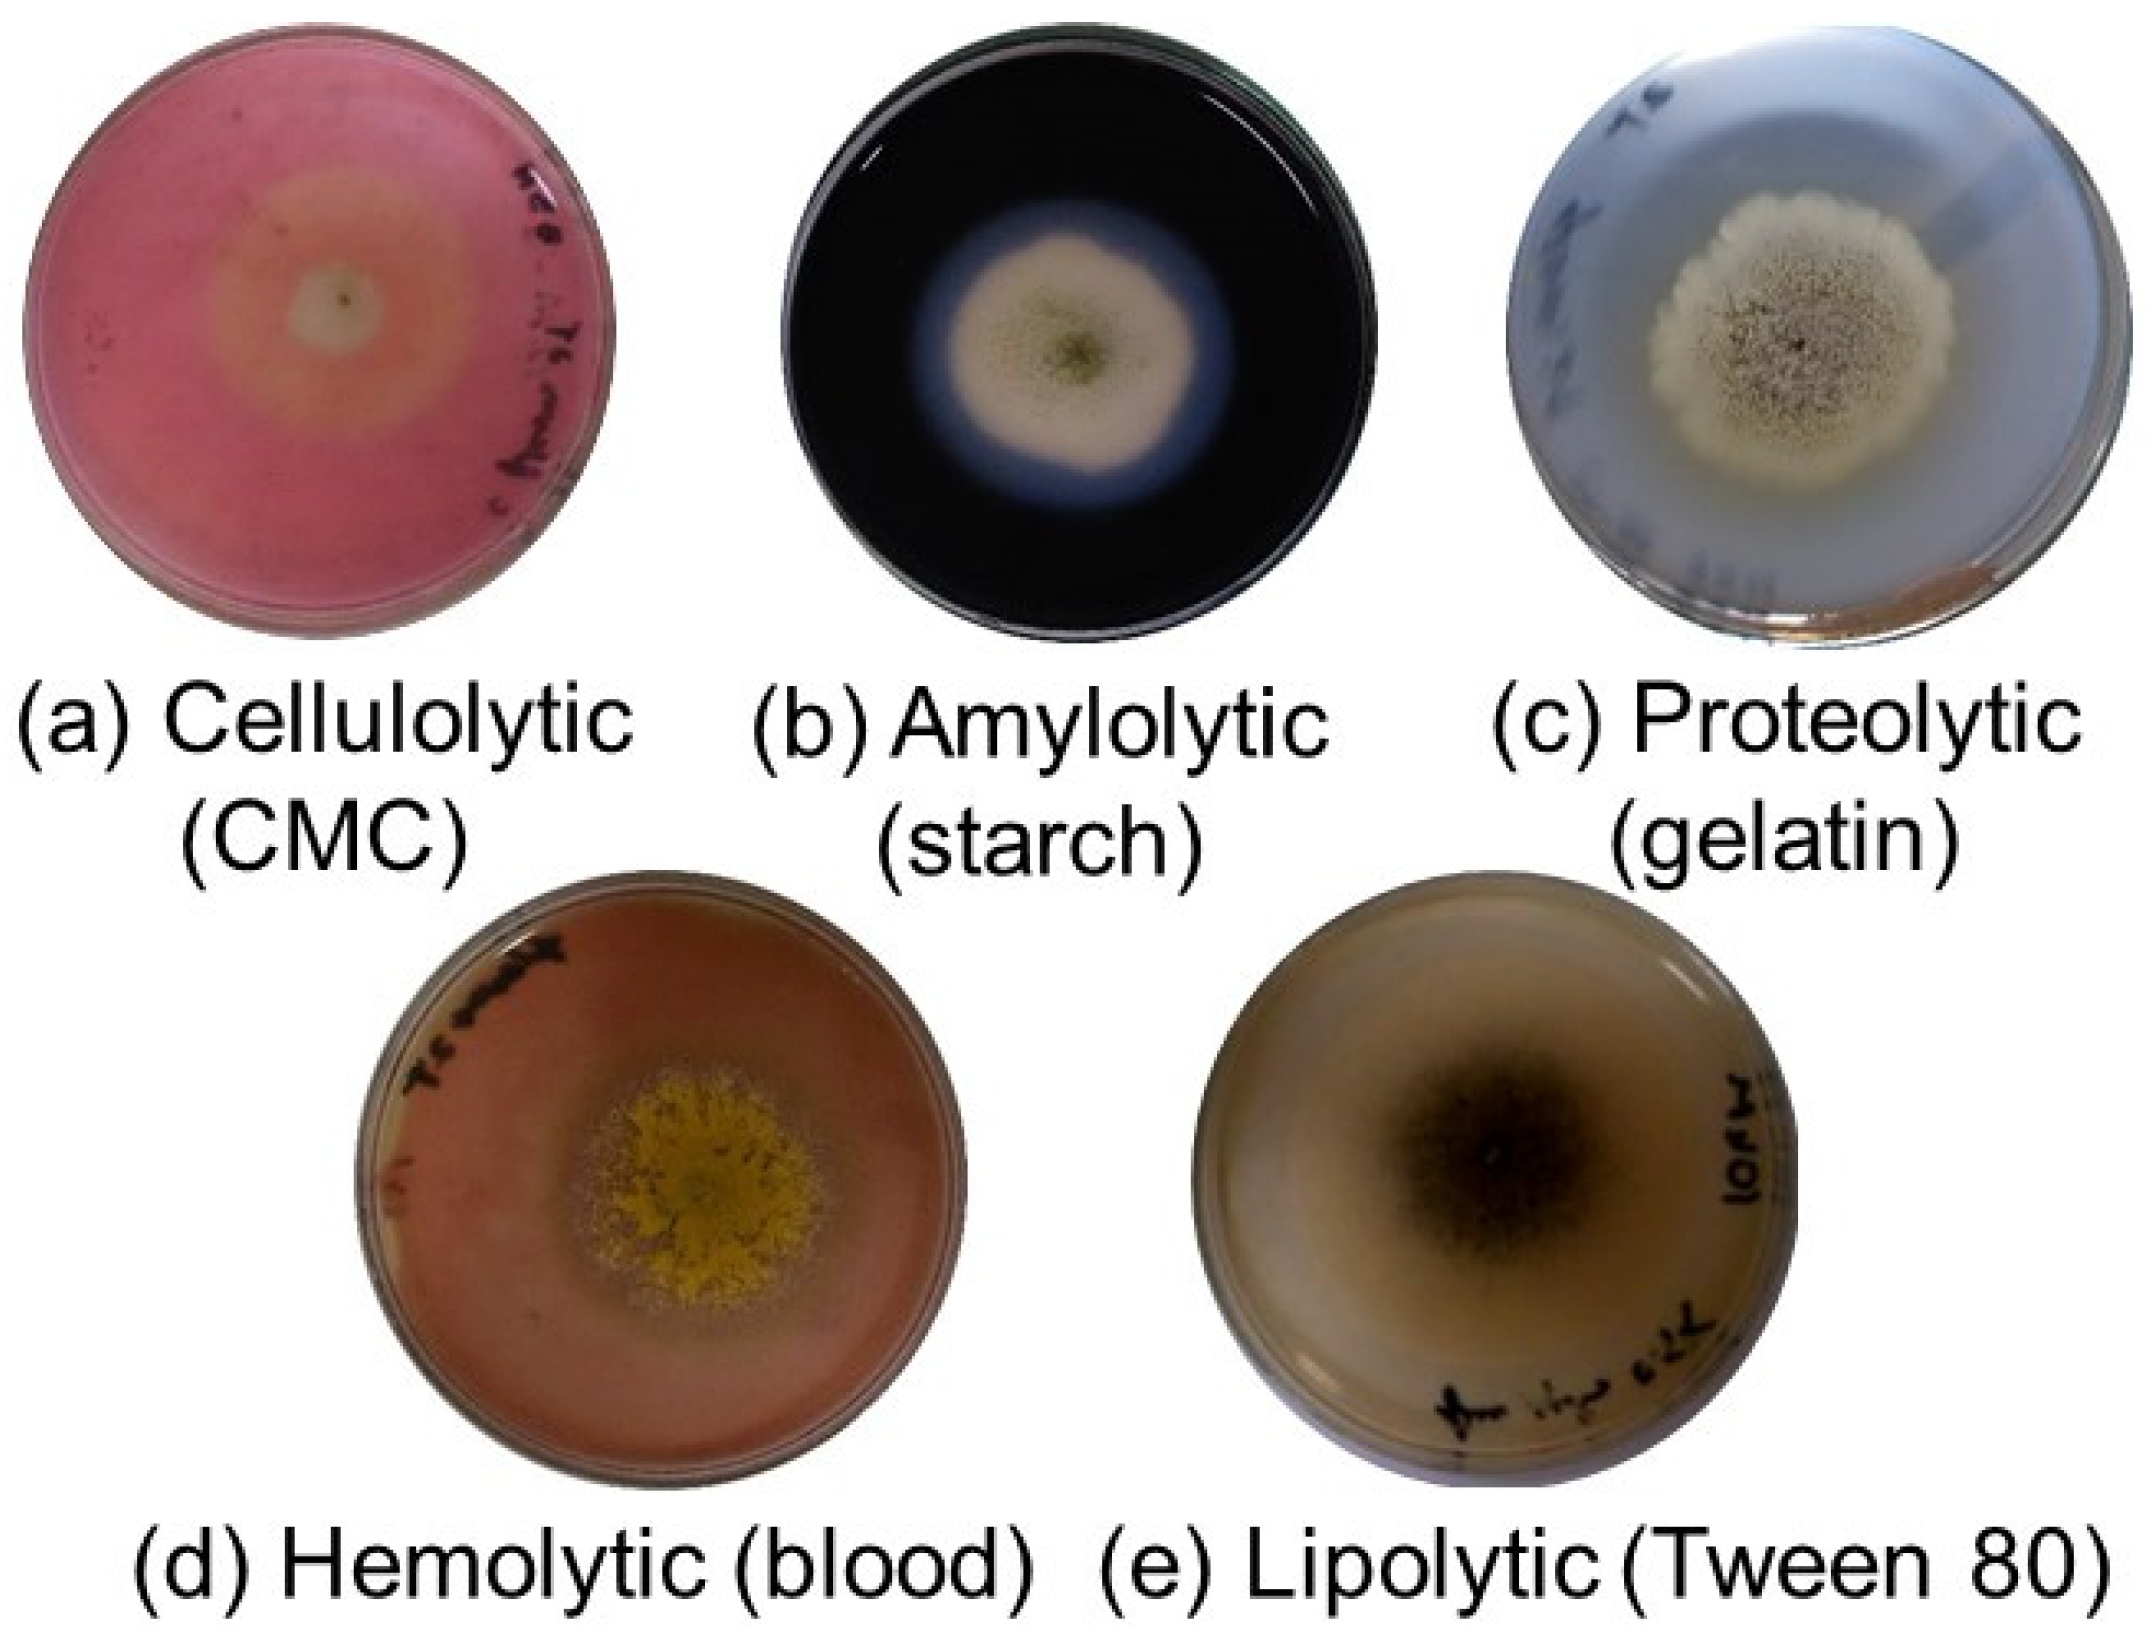
Aerobiology 03 00002 g002
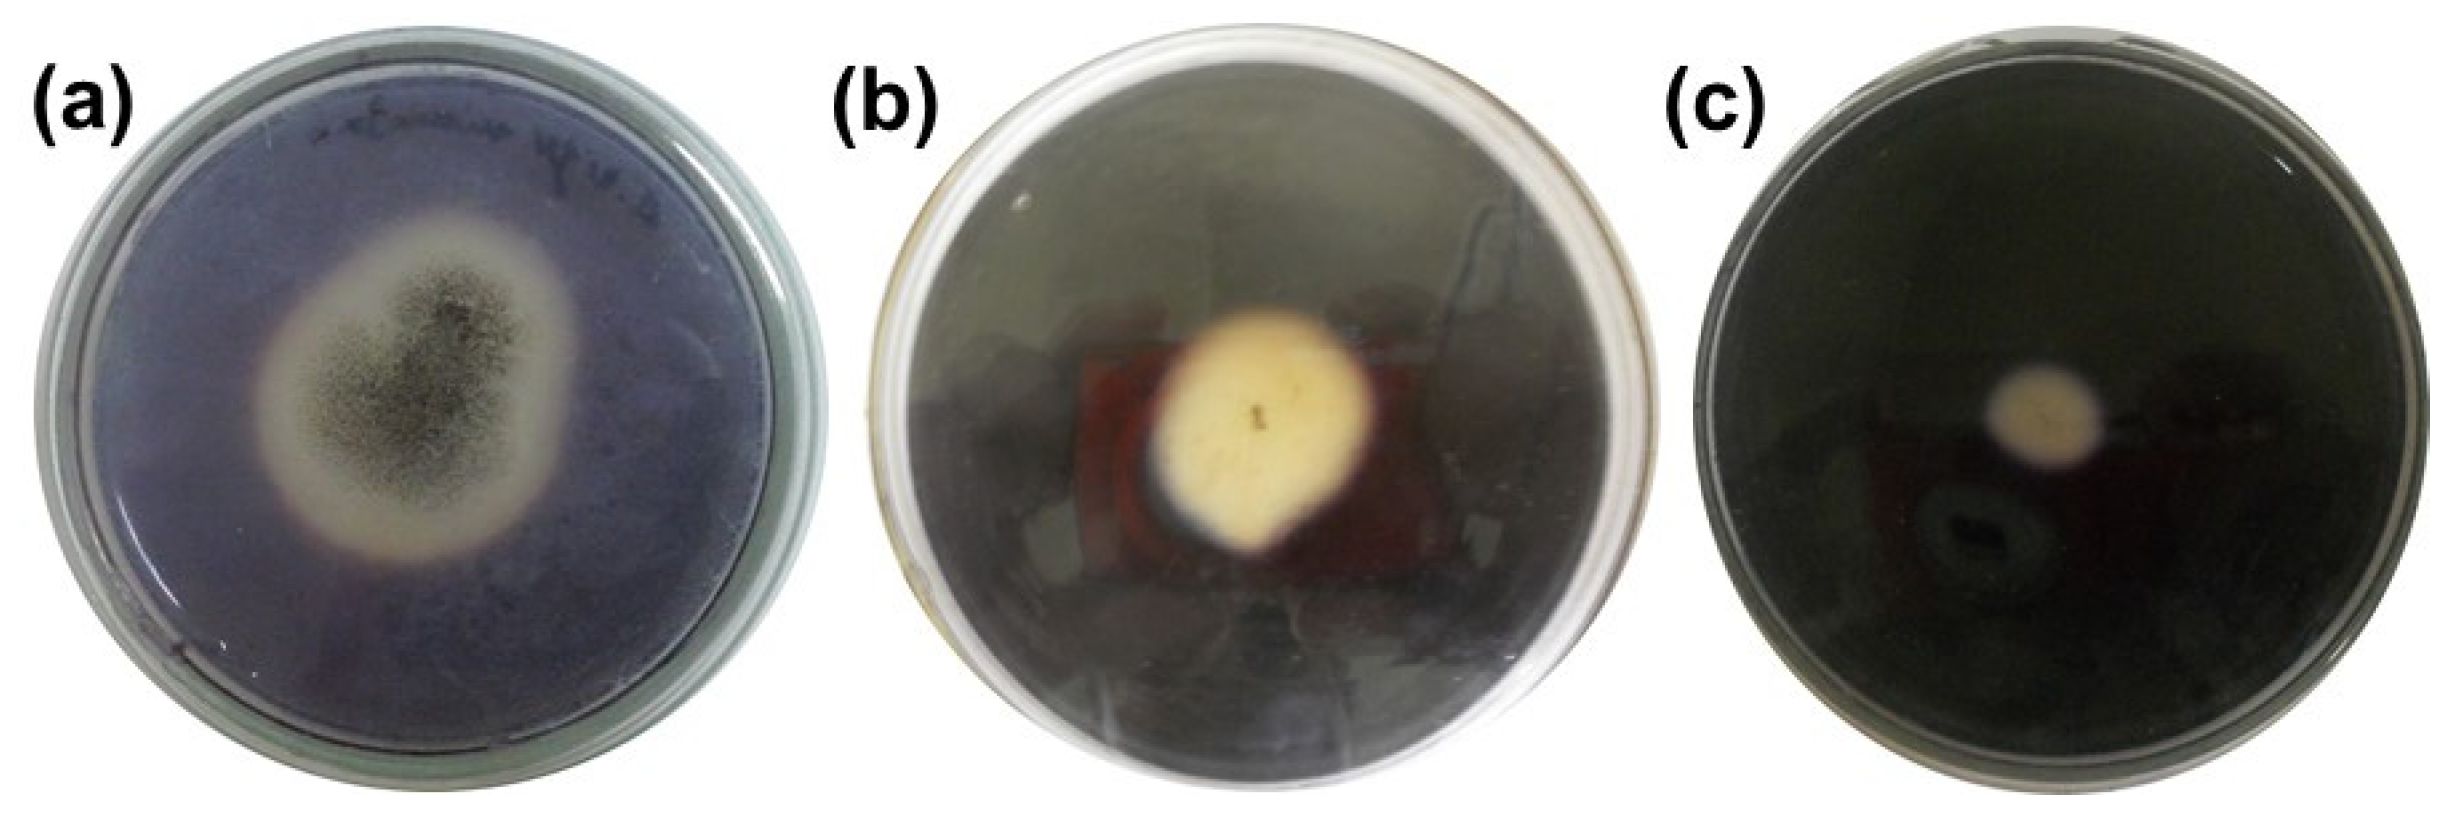
Aerobiology 03 00002 g005

The Effect of a Magnetic Field on the Enzymatic Activities of Common Airborne Aspergillus Strains Isolated from Indoor Environments
Abstract
1. Introduction
2. Materials and Methods
2.1. Selection of Study Strains
2.2. Experimental Design
2.3. Magnetic Treatment
2.4. Determination of Enzymatic Activity
2.5. Exoenzymatic Index
2.6. Statistical Analysis
3. Results
4. Discussion
5. Conclusions
Author Contributions
Funding
Institutional Review Board Statement
Informed Consent Statement
Data Availability Statement
Conflicts of Interest
References
- Anaya, M.; Castro, M.; Borrego, S.; Cobo, H. Influencia del campo magnético sobre la distribución de los hongos en el aire de un local cerrado. Rev. De La Soc. Venez. De Microbiol. 2015, 35, 47–52. [Google Scholar]
- Anaya, M.; Barbará, E.; Padrón, J.; Borrego, S.; Valdés, O.; Molina, A. Influencia del campo magnético sobre el crecimiento de microorganismos patógenos ambientales aislados en el Archivo Nacional de la República de Cuba. Biomédica 2015, 35, 325–336. [Google Scholar] [CrossRef] [PubMed]
- Anaya, M.; Borrego, S.; Gámez, E.; Castro, M.; Valdés, O.; Molina, A. Viable fungi in the air of indoor environments of the National Archive of the Republic of Cuba. Aerobiologia 2016, 32, 513–527. [Google Scholar] [CrossRef]
- Anaya, M.; Borrego, S.; Castro, M.; Valdés, O.; Molina, A. Influence of the 60 Hz magnetic field on the airborne microbial distribution of indoor environments. J. Atmos. Sci. Res. 2020, 03, 23–32. [Google Scholar] [CrossRef]
- Anaya, M.; Gámez, E.; Valdés, O.; Guzmán, T.; Borrego, S. Effect of the oscillating magnetic field on airborne fungal. Arch. Microbiol. 2021, 203, 2139–2145. [Google Scholar] [CrossRef]
- Anaya, M.; Borrego, S.; Castro, M. Considerations about the influence of extremely low frequency oscillating magnetic field on indoor airborne. Rev. CENIC Cienc. Biol. 2021, 52, 079–092. [Google Scholar]
- Anaya, M.; Borrego, S.; Barbará, E. Quantification of superficial growth and the pigmentation of filamentous fungi by effect of oscillating magnetic field. Rev. CENIC Cienc. Biol. 2022, 53, 126–139. [Google Scholar]
- Anaya, M.; Gámez, E.; Borrego, S.; Barbará, E. Magnetotropism: A tropic response of Candida guillemondii by the effect of the oscillating magnetic field of extremely low frequency. Air Qual. Atmos. Health 2023, 16, 2367–2376. [Google Scholar] [CrossRef]
- Razzazi, E.; Rizwan, M.; Mayrhofer, C.; Nöbauer, K. Chapter 7: The use of proteomics as a novel tool in aflatoxin research. In Aflatoxins. Biochemistry and Molecular Biology; InTechOpen: London, UK, 2011; pp. 127–150. [Google Scholar]
- Swee, Y.L.; Dannemiller, K.; Yao, M.; Yamamoto, N.; Peccia, J. The allergenicity of Aspergillus fumigatus conidia is influenced by growth temperature. Fungal Biol. 2011, 115, 625–632. [Google Scholar] [CrossRef]
- Bhunjun, C.; Phukhamsakda, C.; Boekhout, T.; Groenewald, J.; McKenzi, E.; Francisco, E.; Frisvad, J.; Groenewald, M.; Hurdeal, V.; Luangsa-Ard, J.; et al. What are the 100 most cited fungal genera? Stud. Mycol. 2024, 108, 1–412. [Google Scholar] [CrossRef]
- Corbu, V.M.; Gheorghe-Barbu, I.; Dumbravă, A.S.; Vrâncianu, C.O. Current insights in fungal importance. A comprehensive review. Microorganisms 2023, 11, 1384. [Google Scholar] [CrossRef] [PubMed]
- Stewart, G.A.; Robinson, C. Indoor and outdoor allergens and pollutants. In Middleton’s Allergy Essentials; Elsevier: Amsterdam, The Netherlands, 2017; pp. 73–116. [Google Scholar] [CrossRef]
- Maisincho, M.P.; Delgado, M.H.; Cedeño, C.A. Modelos matemáticos en la cinética enzimática. Una revisión. Rev. Cent. Azúcar 2022, 49, 115–131. Available online: http://scielo.sld.cu/pdf/caz/v49n1/2223-4861-caz-49-01-115.pdf (accessed on 10 November 2024).
- Klich, M.A.; Pitt, J.I. A Laboratory Guide to the Common Aspergillus Species and Their Teleomorphs; Commonwealth Scientific and Industrial Research Organization: Canberra, Australia, 1994; 116p. [Google Scholar]
- Simões, M.F.; Santos, C.; Lima, N. Structural diversity of Aspergillus (section Nigri) spores. Microsc. Microanal. 2013, 19, 1151–1158. [Google Scholar] [CrossRef] [PubMed]
- Anaya, M.; Borrego, S.; Cobo, H.; Valdés, O.; Molina, A. Aeromicobiota de un depósito de alimentos en La Habana, Cuba. Augmdomus 2014, 6, 95–110. [Google Scholar]
- Anaya, M.; Gámez, E.; Falco, A.S.; Benítez, E.; Carballo, G. Characterization of indoor air mycobiota of two locals in a food industry, Cuba. Air Qual. Atmos. Health 2019, 12, 797–805. [Google Scholar] [CrossRef]
- Araujo, R.; Rodríguez, A.G.; Pina-Vaz, C. A fast, practical and reproducible procedure for the standardization of the cell density of an Aspergillus suspension. J. Med. Microbiol. 2004, 53, 783–786. [Google Scholar] [CrossRef]
- Borrego, S.; Guiamet, P.; Gómez de Saravia, S.; Batistini, P.; Garcia, M.; Lavin, P.; Perdomo, I. The quality of air at archives and the biodeterioration of photographs. Int. Biodeterior. Biodegrad. 2010, 64, 139–145. [Google Scholar] [CrossRef]
- Borrego, S.; Lavin, P.; Perdomo, I.; Gómez de Saravia, S.; Guiamet, P. Determination of indoor air quality in archives and the biodeterioration of the documentary heritage. ISRN Microbiol. 2012, 2012, 680598. [Google Scholar] [CrossRef]
- Borrego, S.; Molina, A. Behavior of the cultivable airborne mycobiota in air-conditioned environments of three Havanan archives, Cuba. J. Atmos. Sci. Res. 2020, 3, 16–28. [Google Scholar] [CrossRef]
- Bogomolova, E.; Kirtsideli, I. Airborne fungi in four stations of the St. Petersburg underground railway system. Int. Biodeterior. Biodegrad. 2009, 63, 156–160. [Google Scholar] [CrossRef]
- Llop, A.; Valdés, D.; Vivanco, M.M.; Zuazo, J. Microbiología y Parasitología Médica, 3rd ed.; Ciencias Médicas: Havana, Cuba, 2001; Volume 1. [Google Scholar]
- Abdel-Azeem, A.M.; Abdel-Azeem, M.A.; Abdul-Hadi, S.Y.; Darwish, A.G. Aspergillus: Biodiversity, Ecological significances, and industrial applications. In Recent Advancement in White Biotechnology Through Fungi. Fungal Biology; Yadav, A., Mishra, S., Singh, S., Gupta, A., Eds.; Springer: Cham, Switzerland, 2019. [Google Scholar] [CrossRef]
- Veselská, T.; Homutová, K.; Fraile, P.G.; Kubátová, A.; Martínková, N.; Pikula, J.; Kolařík, M. Comparative eco-physiology revealed extensive enzymatic curtailment, lipases production and strong conidial resilience of the bat pathogenic fungus. Pseudogymnoascus destructans. Sci. Rep. 2020, 10, 16530. [Google Scholar] [CrossRef]
- Amaya, O.J.; Díaz, A. Caracterización de hongos productores de enzimas lipasas. Cienc. E Ing. 2022, 9, e6708445. [Google Scholar] [CrossRef]
- Makarov, I.O.; Llyuev, D.D.; Smirnov, V.F. Effect of low frequency pulsed magnetic field and low-level laser radiation on oxidoreductase activity and growth of fungi-active destructors of polymer materials. Microbiology 2019, 88, 72–78. [Google Scholar] [CrossRef]
- Knutsen, A.P.; Bush, R.K.; Demain, J.G.; Denning, D.W.; Dixit, A.; Fairs, A.; Greenberger, P.A.; Kariuki, B.; Kita, H.; Kurup, V.P.; et al. Fungi and allergic lower respiratory tract diseases. J. Allergy Clin. Immunol. 2012, 129, 280–291. [Google Scholar] [CrossRef] [PubMed]
- Li, W.; Haile, M.; Ronghai, H.; Xiaofeng, R.; Zhou, C. Prospects and application of ultrasound and magnetic fields in the fermentation of rare edible fungi. Ultrason. Sonochem. 2021, 76, 105613. [Google Scholar] [CrossRef]
- Aboneima, S.M.; El-Metwally, M. Effect of extremely low frequency magnetic field in growth, CM case, electric conductivity and DNA of Aspergillus niger. Egypt. J. Phys. 2021, 49, 15–34. [Google Scholar] [CrossRef]
- Escobaro, A.M.; Pizzioa, L.R.; Romanelli, G.P. Catalizadores magnéticos basados en óxidos de hierro: Síntesis, propiedades y aplicaciones. Cienc. En Desarro. 2019, 10, 79–101. [Google Scholar] [CrossRef]
- Liu, J.; Wang, D.; Wang, H.; Yang, N.; Hou, J.; Lv, X.; Gong, L. Low frequency magnetic field assisted production of acidic protease by Aspergillus niger. Arch. Microbiol. 2024, 206, 273. [Google Scholar] [CrossRef]
- Mayura, V.; Nan-Nan, Y.; Sin-Jin, B.; Ikhwan, K. Enhancement oh fungal enzyme production by radio-frequency electromagnetic fields. J. Fungi 2022, 8, 1187. [Google Scholar] [CrossRef]
- Hashim, M.S. Effect of Static Magnetic Field on Amylase and Protease Produced by Some Fungal Isolates Using Solid State Fermentation. Master’s Thesis, Department of Biotechnology, College of Science, Al-Nahrain University, Baghdad, Iraq, 2016. Available online: https://www.nahrainuniv.edu.iq/sites/default/files/%D8%A7%D9%84%D8%A7%D8%B7%D8%B1%D9%88%D8%AD%D8%A9%20%D9%83%D8%A7%D9%85%D9%84%D8%A9.pdf (accessed on 23 October 2024).
- Aiman, M.A.; Abdul, G.I.Y.; Abdul, W.S.J. Effect of magnetic field energy on growth of Aspergillus flavus and aflatoxins production. J. Al-Nahrain Univ. 2013, 16, 180–187. [Google Scholar] [CrossRef]
- Chen, W.; Zhang, Y.; Shi, Z. Effect of extremely low frequency electromagnetic field on the pathogenicity of Magnaporthe oryzae. Sci. Total Environ. 2023, 870, 161939. [Google Scholar] [CrossRef] [PubMed]
- Sztafrowski, D.; Muraszko, J.; Jasiura, A.; Bryk, P.; Urbanek, A.K.; Krasowska, A. The alternating 50 Hz magnetic field depending on the hydrophobicity of the strain affects the viability, filamentation and sensitivity to drugs of Candida albicans. PLoS ONE 2023, 18, e0291438. [Google Scholar] [CrossRef] [PubMed]
- Cairns, T.C.; Zheng, X.; Zheng, P.; Sun, J.; Meyer, V. Turning inside out: Filamentous fungal secretion and its applications in biotechnology, agriculture, and the clinic. J. Fungi 2021, 7, 535. [Google Scholar] [CrossRef] [PubMed]
- Zhang, N.; Zhang, H.; Khan, L.A.; Jafari, G.; Eun, Y.; Membreno, E.; Gobel, V. The biosynthetic-secretory pathway, supplemented by recycling routes, determines epithelial membrane polarity. Sci. Adv. 2023, 9, 4620. [Google Scholar] [CrossRef]
- Jadhav, R.; Mach, R.L.; Mach-Aigner, A.R. Protein secretion and associated stress in industrially employed filamentous fungi. Appl. Microbiol. Biotechnol. 2024, 108, 92. [Google Scholar] [CrossRef]
- Shunk, G.K.; Gómez, X.R.; Averesch, N.J.H. A self-replicating radiation-shield for human deep-space exploration: Radiotrophic fungi can attenuate ionizing radiation aboard the international space station. BioRxiv 2020. [Google Scholar] [CrossRef]

| Density of ELF-OMF [mT] (A) | Time of ELF-OMF [min] (B) | Fungal Strain (C) |
|---|---|---|
| 0.5 (low) | 30.0 (low) | A. flavus |
| 2.0 (high) | 120.0 (high) | A. fumigatus |
| A. ellipticus | ||
| A. japonicus |
| Fungal Strain (C) | Run No. | Time [min] (B) | ELF-OMF [mT] (A) | Icel | Iamil | Iprot | Ihem | Ilip | pH |
|---|---|---|---|---|---|---|---|---|---|
| A. ellipticus | 1 | 120 | 0.50 | 0.58 | 0.56 | 0.56 | 0.53 | 0.51 | 5.90 |
| 2 | 30 | 0.90 | 0.56 | 0.57 | 0.53 | 0.54 | 0.52 | 5.70 | |
| 3 | 75 | 1.30 | 0.54 | 0.53 | 0.51 | 0.53 | 0.52 | 5.88 | |
| 4 | 75 | 1.30 | 0.55 | 0.54 | 0.52 | 0.52 | 0.51 | 5.90 | |
| 5 | 30 | 2.00 | 0.54 | 0.55 | 0.51 | 0.54 | 0.52 | 5.50 | |
| 6 | 120 | 2.00 | 0.55 | 0.55 | 0.50 | 0.55 | 0.50 | 5.33 | |
| A. japonicus | 7 | 30 | 0.50 | 0.61 | 0.60 | 0.51 | 0.55 | 0.58 | 6.50 |
| 8 | 120 | 0.50 | 0.62 | 0.59 | 0.52 | 0.54 | 0.56 | 6.60 | |
| 9 | 98 | 1.30 | 0.60 | 0.51 | 0.52 | 0.56 | 0.52 | 6.54 | |
| 10 | 98 | 1.30 | 0.61 | 0.49 | 0.53 | 0.57 | 0.53 | 6.63 | |
| 11 | 30 | 2.00 | 0.62 | 0.53 | 0.52 | 0.56 | 0.53 | 6.40 | |
| 12 | 120 | 2.00 | 0.63 | 0.53 | 0.54 | 0.57 | 0.54 | 6.58 | |
| A. flavus | 13 | 74 | 0.50 | 0.61 | 0.58 | 0.57 | 0.56 | 0.52 | 6.69 |
| 14 | 74 | 0.50 | 0.61 | 0.58 | 0.57 | 0.55 | 0.51 | 6.74 | |
| 15 | 120 | 1.20 | 0.63 | 0.59 | 0.58 | 0.55 | 0.52 | 5.93 | |
| 16 | 30 | 1.30 | 0.62 | 0.58 | 0.58 | 0.56 | 0.51 | 5.90 | |
| 17 | 120 | 2.00 | 0.64 | 0.58 | 0.57 | 0.57 | 0.52 | 5.95 | |
| 18 | 33 | 2.00 | 0.63 | 0.58 | 0.58 | 0.56 | 0.52 | 5.83 | |
| 19 | 77 | 2.00 | 0.64 | 0.59 | 0.59 | 0.57 | 0.53 | 5.90 | |
| A. fumigatus | 20 | 106 | 0.50 | 0.51 | 0.52 | 0.52 | 0.57 | 0.52 | 6.51 |
| 21 | 106 | 0.50 | 0.53 | 0.53 | 0.51 | 0.56 | 0.51 | 6.51 | |
| 22 | 60 | 1.40 | 0.52 | 0.50 | 0.52 | 0.56 | 0.52 | 6.00 | |
| 23 | 60 | 1.40 | 0.51 | 0.51 | 0.51 | 0.57 | 0.53 | 6.02 | |
| 24 | 30 | 2.00 | 0.53 | 0.51 | 0.51 | 0.58 | 0.53 | 6.50 | |
| 25 | 120 | 2.00 | 0.52 | 0.51 | 0.51 | 0.57 | 0.53 | 6.53 |
| Factor | p Value (for 95% Confidence) | ||
|---|---|---|---|
| Exoenzymatic Index | |||
| Cellulolytic | Amylolytic | Lipolytic | |
| A | - | - | - |
| B | 0.0060 | 0.0146 | 0.0074 |
| C | 0.0001 | 0.0339 | - |
| AC | 0.0081 | - | - |
| BC | 0.0085 | - | 0.0305 |
| A2 | 0.0001 | 0.0121 | - |
| B2 | 0.0092 | - | - |
| Index | Strain | Adjusted Mathematical Models | R2 |
|---|---|---|---|
| Cellulolytic | A. ellipticus | 0.54 + 0.13 B + 0.05 AB − 0.01 A2 − 0.04 B2 | 0.9167 |
| A. japonicus | 0.75 + 0.06 B + 0.05 AB − 0.01 A2 − 0.04 B2 | ||
| A. flavus | 0.71 + 0.07 B + 0.05 AB − 0.01 A2 − 0.04 B2 | ||
| A. fumigatus | 0.63 + 0.08 B + 0.05 AB − 0.01 A2 − 0.04 B2 | ||
| Amylolytic | A. ellipticus | 0.50 + 0.04 B + 0.05 A2 | 0.7998 |
| A. japonicus | 0.66 + 0.02 B + 0.05 A2 | ||
| A. flavus | 0.65 + 0.04 B + 0.05 A2 | ||
| A. fumigatus | 0.59 − 0.02 B + 0.05 A2 | ||
| Lipolytic | A. ellipticus | 0.54 − 0.09 B | 0.6975 |
| A. japonicus | 0.51 − 0.09 B | ||
| A. flavus | 0.55 − 0.05 B | ||
| A. fumigatus | 0.59 − 0.07 B |
Disclaimer/Publisher’s Note: The statements, opinions and data contained in all publications are solely those of the individual author(s) and contributor(s) and not of MDPI and/or the editor(s). MDPI and/or the editor(s) disclaim responsibility for any injury to people or property resulting from any ideas, methods, instructions or products referred to in the content. |
© 2025 by the authors. Licensee MDPI, Basel, Switzerland. This article is an open access article distributed under the terms and conditions of the Creative Commons Attribution (CC BY) license (https://creativecommons.org/licenses/by/4.0/).
Share and Cite
Anaya-Villalpanda, M.; Gámez-Espinosa, E.; Borrego-Alonso, S. The Effect of a Magnetic Field on the Enzymatic Activities of Common Airborne Aspergillus Strains Isolated from Indoor Environments. Aerobiology 2025, 3, 2. https://doi.org/10.3390/aerobiology3010002
Anaya-Villalpanda M, Gámez-Espinosa E, Borrego-Alonso S. The Effect of a Magnetic Field on the Enzymatic Activities of Common Airborne Aspergillus Strains Isolated from Indoor Environments. Aerobiology. 2025; 3(1):2. https://doi.org/10.3390/aerobiology3010002
Chicago/Turabian StyleAnaya-Villalpanda, Matilde, Erasmo Gámez-Espinosa, and Sofía Borrego-Alonso. 2025. "The Effect of a Magnetic Field on the Enzymatic Activities of Common Airborne Aspergillus Strains Isolated from Indoor Environments" Aerobiology 3, no. 1: 2. https://doi.org/10.3390/aerobiology3010002
APA StyleAnaya-Villalpanda, M., Gámez-Espinosa, E., & Borrego-Alonso, S. (2025). The Effect of a Magnetic Field on the Enzymatic Activities of Common Airborne Aspergillus Strains Isolated from Indoor Environments. Aerobiology, 3(1), 2. https://doi.org/10.3390/aerobiology3010002

